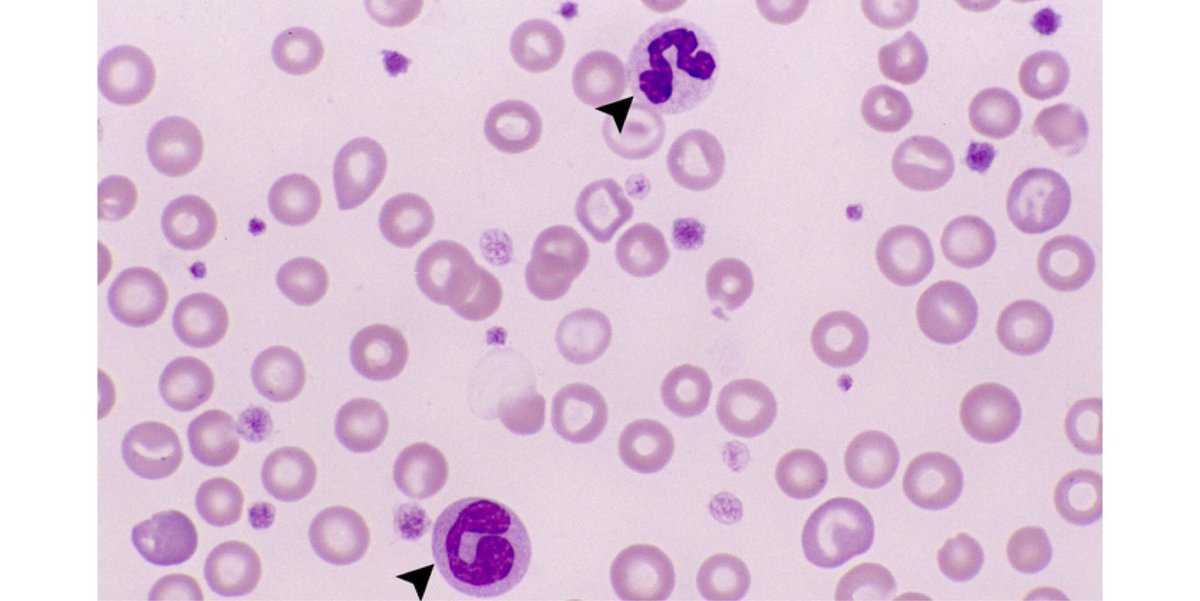

فحص تعداد الدم الكامل (CBC)
يعتبر فحص تعداد الدم الكامل (CBC) اختبار دم يستخدم لتقييم الحالة الصحية العامة والكشف عن مجموعة كبيرة من الاضطرابات، بما في ذلك فقر الدم والعدوى وابيضاض الدم.
يعتبر فحص تعداد الدم الكامل (CBC) اختبار دم يستخدم لتقييم الحالة الصحية العامة والكشف عن مجموعة كبيرة من الاضطرابات، بما في ذلك فقر الدم والعدوى وابيضاض الدم.
ماذا تعني نتائج الاختبار؟
ارتفاع عدد خلايا الدم الحمراء RBC
تتضمن بعض أسباب ارتفاع عدد خلايا الدم الحمراء ما يلي:
•التعرض لأول أكسيد الكربون
•التدخين
•مرض الرئة المزمن
•اضطراب تعاطي الكحول
•أمراض القلب
•مرض كلوي
•مرض الكبد
ارتفاع عدد خلايا الدم الحمراء RBC
تتضمن بعض أسباب ارتفاع عدد خلايا الدم الحمراء ما يلي:
•التعرض لأول أكسيد الكربون
•التدخين
•مرض الرئة المزمن
•اضطراب تعاطي الكحول
•أمراض القلب
•مرض كلوي
•مرض الكبد
انخفاض عدد خلايا الدم الحمراء RBC
تتضمن بعض أسباب انخفاض عدد خلايا الدم الحمراء ما يلي:
•فقر دم
•نزيف
•مرض التهاب الأمعاء
•استخدام بعض الأدوية
•اضطرابات نخاع العظام
•فشل كلوي مزمن
•نقص الحديد، نقص فيتامين B12 ، أو نقص حمض الفوليك
تتضمن بعض أسباب انخفاض عدد خلايا الدم الحمراء ما يلي:
•فقر دم
•نزيف
•مرض التهاب الأمعاء
•استخدام بعض الأدوية
•اضطرابات نخاع العظام
•فشل كلوي مزمن
•نقص الحديد، نقص فيتامين B12 ، أو نقص حمض الفوليك
ارتفاع عدد خلايا الدم البيضاء WBC
يحدث ارتفاع في عدد خلايا الدم البيضاء بسبب:
•عدوى
•التهاب
•استخدام الدواء
•حالة مناعية
•إصابة
•سرطان
•حمل
•التدخين
•ردود الفعل التحسسية
يحدث ارتفاع في عدد خلايا الدم البيضاء بسبب:
•عدوى
•التهاب
•استخدام الدواء
•حالة مناعية
•إصابة
•سرطان
•حمل
•التدخين
•ردود الفعل التحسسية
يحدث انخفاض في عدد خلايا الدم البيضاء بسبب:
•اضطرابات نخاع العظام
•ظروف المناعة الذاتية
•عدوى شديدة، مثل تعفن الدم
•سرطان الغدد الليمفاوية، وهو نوع من السرطان
•النقص الغذائي
•الحالات التي تؤثر على جهاز المناعة، مثل فيروس نقص المناعة البشرية أو الإيدز
•اضطرابات نخاع العظام
•ظروف المناعة الذاتية
•عدوى شديدة، مثل تعفن الدم
•سرطان الغدد الليمفاوية، وهو نوع من السرطان
•النقص الغذائي
•الحالات التي تؤثر على جهاز المناعة، مثل فيروس نقص المناعة البشرية أو الإيدز
الصفائح الدموية Platelets
يحدث ارتفاع عدد الصفائح الدموية يرجع إلى:
•الشفاء من الإصابة أو الجراحة
•نقص فيتامين ب 12
•سرطان
•فقر دم
•حالات التهابية
•الالتهابات
•فقر دم
يحدث ارتفاع عدد الصفائح الدموية يرجع إلى:
•الشفاء من الإصابة أو الجراحة
•نقص فيتامين ب 12
•سرطان
•فقر دم
•حالات التهابية
•الالتهابات
•فقر دم
تتضمن بعض أسباب انخفاض عدد الصفائح الدموية ما يلي:
•بعض الأدوية
•سرطان
•فقر دم
•الفيروسات
•الالتهابات
•العلاج الكيميائي
•نزيف مزمن
•ظروف المناعة الذاتية
•بعض الأدوية
•سرطان
•فقر دم
•الفيروسات
•الالتهابات
•العلاج الكيميائي
•نزيف مزمن
•ظروف المناعة الذاتية
متى يتم فحص تعداد الدم الكامل CBC
• قد يطلبه الطبيب أثناء الفحص الروتيني أو إذا كانت هناك علامات وأعراض لمشكلة كامنة.
• يمكن للأشخاص الذين يخضعون للعلاج من الحالات المزمنة زيارة الطبيب بانتظام للحصول على الفحص.
• يجب على أي شخص يعاني من أعراض مستمرة زيارة الطبيب لإجراء الفحص
• قد يطلبه الطبيب أثناء الفحص الروتيني أو إذا كانت هناك علامات وأعراض لمشكلة كامنة.
• يمكن للأشخاص الذين يخضعون للعلاج من الحالات المزمنة زيارة الطبيب بانتظام للحصول على الفحص.
• يجب على أي شخص يعاني من أعراض مستمرة زيارة الطبيب لإجراء الفحص
جاري تحميل الاقتراحات...